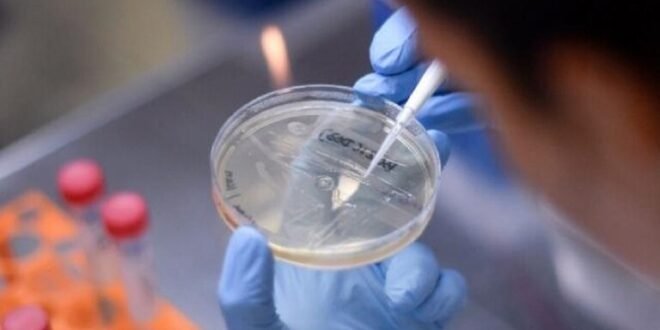

منبر العراق الحر :
كشفت بيانات صادرة عن مراكز أمريكية ناشطة في مكافحة الأمراض عن زيادة معدلات الإصابة بعدوى “نوروفيروس” المصنف كأكثر الأسباب شيوعا لالتهاب المعدة والأمعاء الحاد.
وذكرت شبكة “سي إن إن” أن بيانات مركز السيطرة على الأمراض أظهرت أنه في الأسبوع المنتهي في 17 فبراير جاءت أكثر من 12% من اختبارات “نوروفيروس” إيجابية.
وأشارت البيانات إلى أن “الحالات ترتفع بشكل خاص في الشمال الشرقي من البلاد، حيث جاءت أكثر من 13% من الاختبارات إيجابية.
وأوضحت البيانات أن “هذه المستويات أقل مما كانت عليه في ذات التوقيت من الموسم الماضي، إذ كانت حوالي 15% من الاختبارات إيجابية، على مستوى البلاد”.
ويعد تفشي “نوروفيروس” أكثر شيوعا في أواخر الخريف والشتاء وأوائل الربيع.
ووفقا لمركز السيطرة على الأمراض، يصيب “نوروفيروس” ما بين 19 مليونا إلى 21 مليون حالة إصابة كل عام وخاصة في البيئات المزدحمة مثل دور رعاية المسنين ومراكز الرعاية والسفن السياحية.
وذكر المركز أن عدوى “نوروفيروس” يمكن أن تنتشر عندما يلامس الشخص بشكل مباشر شخصا مصابا، أو عندما يتناول طعاما أو سوائل ملوثة بالفيروس، أو يلمس الأسطح الملوثة، ثم يضع أصابعه في فمه.
وحذر مركز السيطرة على الأمراض (CDC) من أن “الشخص المصاب يمكن أن ينشر “نوروفيروس” بعد أسبوعين أو أكثر من اختفاء الأعراض”.
ويشير المركز إلى أن “الأعراض الأكثر شيوعا هي الإسهال والقيء والغثيان وآلام المعدة”.
وأوضحت الشبكة الأمريكية أنه لا يوجد علاج محدد لعدوى “نوروفيروس” وينصح بشرب الكثير من السوائل لتجنب الجفاف وللوقاية من المرض، كما يوصى بغسل اليدين والفواكه والخضراوات وطهي المحار جيدا.
وفي يناير الماضي، أصدرت إدارة الغذاء والدواء الأمريكية تحذيرا من بيع واستهلاك بعض المحار من كاليفورنيا والمكسيك بسبب احتمال تلوثه بـ”نوروفيروس”.
وفي ديسمبر تم ربط أكثر من 200 حالة يشتبه في إصابتها بـ”نوروفيروس” بمطعم سوشي في ولاية كارولينا الشمالية.
المصدر: “سي إن إن”
 منبر العراق الحر منبر العراق الحر
منبر العراق الحر منبر العراق الحر